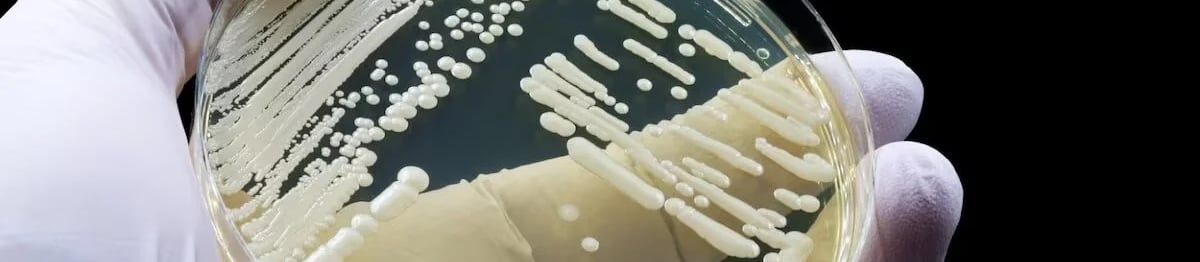
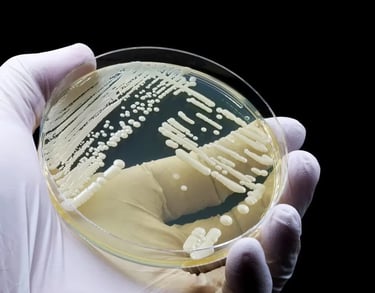

Campanha de vacinação nas escolas do Paraná é prorrogada
Campanha de vacinação nas escolas do Paraná é prorrogada. Prorrogada até o fim de agosto, a campanha de vacinação nas escolas do Paraná não é só uma questão de saúde, mas de aprendizado. Entre agulhas e carteirinhas, alunos, pais e professores se unem para garantir um futuro mais protegido e consciente. Afinal, saúde também se aprende na escola.
NA MÍDIA


Campanha de vacinação nas escolas do Paraná é prorrogada
Quem tem medo de agulha agora ganhou um prazo extra para superar o pânico: a Secretaria de Estado da Saúde (Sesa) anunciou que a campanha de vacinação nas escolas do Paraná foi prorrogada até o dia 31 de agosto. A parceria entre a Sesa e a Secretaria da Educação (Seed) visa garantir que o máximo possível de crianças, adolescentes e jovens saiam das salas de aula com mais do que o boletim em mãos — um certificado de imunização também é o objetivo.
O esforço se estende a 3.276 instituições de ensino estaduais e municipais, abrangendo desde os pequenos nas creches até os mais crescidinhos do ensino médio, espalhados pelas 399 cidades do Estado. Se você achou que a prorrogação foi uma decisão de última hora, pense de novo: a ideia é garantir que ninguém fique de fora, nem mesmo aquele estudante que, por acaso, estava "doente" no dia da vacina. Afinal, a picadinha pode até dar um susto, mas é um preço pequeno a se pagar pela saúde.
Com mais duas semanas no calendário, a campanha se reafirma como uma corrida contra o tempo e a desinformação, onde o prêmio é a imunidade coletiva. Então, se você conhece um aluno que ainda não arregaçou as mangas, é hora de dar aquele empurrãozinho — para o bem dele e de todos.
Desde o dia 5 de agosto, as escolas do Paraná se transformaram em postos avançados de saúde pública, com agulhas em punho e a missão clara: imunizar o máximo de alunos possível. A operação começou com a vacina contra a Influenza, mas logo se expandiu para outras frentes de batalha. Os pequenos e os grandinhos estão sendo convocados a atualizar o arsenal contra doenças que preferimos deixar no passado, como coqueluche, difteria, tétano e hepatite B.
A lista de reforços inclui a pentavalente, a pneumocócica 10, a poliomielite, a DTP e o HPV. É como montar uma defesa completa, para que os invasores microscópicos não tenham vez. E é aí que entra a importância de cada dose aplicada — cada picadinha é um passo na direção de um Paraná mais protegido.
César Neves, o secretário estadual da Saúde, tem a missão de não apenas manter a roda girando, mas fazê-la acelerar. "As nossas coberturas vacinais ainda não estão onde queremos, mas estamos lutando para melhorar. O apoio da Secretaria da Educação é fundamental para continuar essa ofensiva. Queremos que os pais entendam que a vacinação é uma questão de responsabilidade e que eles incentivem seus filhos a se protegerem."
Com os números ainda sendo consolidados, a expectativa é de que a prorrogação traga resultados positivos, consolidando a campanha como uma verdadeira blitz contra as doenças.
Roni Miranda, o comandante da educação no Paraná, tem uma visão clara: uma sala de aula cheia é o primeiro passo para o aprendizado, mas para isso, os alunos precisam estar saudáveis. "Doenças infecciosas não só derrubam o estudante na cama, mas também causam um efeito dominó que afeta o ensino como um todo. A prorrogação dessa campanha de imunização é uma aposta dupla — estamos protegendo a saúde e o futuro dos nossos meninos e meninas," destacou o secretário.
A lógica é simples: prevenir é ensinar.
E como em toda boa lição, a participação dos pais é fundamental.
Cada dose aplicada depende do consentimento deles, formalizado através de um termo assinado. As equipes de saúde, com a mesma minúcia de um professor corrigindo provas, analisam a carteirinha de vacinação de cada estudante, para garantir que ninguém saia sem a lição de casa feita.
A vacina contra a Influenza, a estrela da campanha, está garantida em todas as escolas participantes. Já os outros imunizantes, aqueles que preenchem as lacunas no histórico vacinal dos alunos, variam de acordo com a logística e a estratégia de distribuição de cada município.
Com pais, professores e profissionais da saúde alinhados, a campanha se torna mais do que uma medida sanitária: é uma verdadeira aula prática sobre a importância da prevenção, mostrando que saúde e educação caminham juntas na construção de um futuro melhor.
No final das contas, a prorrogação da campanha de vacinação nas escolas do Paraná é mais do que uma extensão de prazo; é uma reafirmação de valores. Ensinar os alunos sobre a importância da saúde é uma lição que transcende a sala de aula. Afinal, de que adianta uma boa nota se a saúde está em risco?
Ao envolver pais, professores, e autoridades de saúde, o estado do Paraná não está apenas combatendo doenças, mas também promovendo uma cultura de cuidado e responsabilidade. É um esforço coletivo para garantir que cada estudante tenha a chance de frequentar as aulas sem interrupções e de aprender sem as barreiras impostas por doenças evitáveis.
E, como toda boa lição, essa campanha traz um aprendizado para todos: a saúde é um pilar essencial na construção de qualquer sociedade. Ao final do mês, quando a campanha se encerrar, espera-se que os números mostrem mais do que doses aplicadas — que revelem um avanço na consciência coletiva sobre a importância da vacinação.
Assim, o Paraná segue dando seu exemplo, mostrando que quando educação e saúde se encontram, quem ganha é o futuro. E talvez, no próximo ano, as filas para a vacina sejam ainda maiores, não porque as doenças aumentaram, mas porque a lição foi bem aprendida.